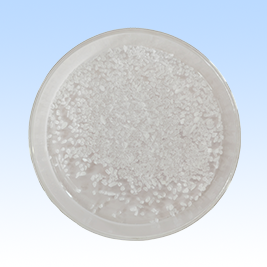
Méthylsulfonylméthane

Méthylsulfonylméthane
Diméthylsulfone (MSM)
N° CAS : 67-71-0
Formule chimique : C₂H₆O₂S
Pureté : ≥99,9 %
Paquet : 25 kg/sac et personnalisé
Code SH : 290410
Présentation du produit
Le diméthylsulfone (MSM), également connu sous le nom de méthylsulfonylméthane, est un composé soufré organique de haute pureté largement utilisé dans les produits pharmaceutiques, nutraceutiques, cosmétiques et les applications industrielles. Grâce à sa structure cristalline stable et à sa solubilité exceptionnelle, le MSM est un ingrédient polyvalent pour les compléments alimentaires, les formules de soins de la peau et les procédés chimiques avancés.

Principaux avantages du produit :
1. Ultra-haute pureté
Le MSM de qualité pharmaceutique (pureté ≥ 99,9 %) garantit la conformité aux normes USP, Ph. Eur. et autres normes internationales.
Faibles niveaux d'endotoxines et limites microbiennes pour des applications critiques comme les produits injectables et la thérapie cellulaire.
2. Compatibilité multisectorielle
Soluble dans l'eau (150 g/L à 20°C) et les solvants organiques, idéal pour les formulations liquides, les API et la synthèse de polymères.
Stable à haute température (point de fusion : 107–109 °C) et non réactif avec la plupart des produits chimiques.
3. Production respectueuse de l'environnement
Fabriqué selon des procédés respectueux de l'environnement avec un minimum de déchets et de consommation d'énergie.
4. Solutions personnalisables
Disponible en grandes quantités (fûts de 25 kg, barils de 200 kg) ou en petits lots pour la R&D, avec des options d'emballage flexibles.

Applications
1. Santé et nutrition :
Compléments alimentaires pour la santé des articulations pour le soulagement de l’arthrite et la synthèse du collagène2.
Source de soufre organique dans les aliments fonctionnels et les additifs pour aliments pour animaux27.
2. Cosmétiques et soins de la peau :
Améliore l'élasticité de la peau et la résistance des cheveux et des ongles dans les crèmes, sérums et shampooings anti-âge2.
3. Industrie et chimie :
Solvant pour réactions à haute température, modification de polymères et synthèse de pesticides28.
Réactif analytique en chromatographie et recherche en science des matériaux58.
4. Produits pharmaceutiques :
Excipient dans les formulations topiques pour une meilleure pénétration des médicaments et la cryoconservation des cultures cellulaires.

Pourquoi nous choisir ?
1. Fabricant certifié
Les installations de production ISO 9001 et GMP garantissent une conformité mondiale.
2. Logistique mondiale rapide
Expédition efficace vers l'Amérique du Nord, l'Europe et l'Asie avec des MOQ compétitifs et une flexibilité Incoterms.
3. Support technique
CoA, FDS et tests d'échantillons gratuits. Spécifications de granulométrie et de pureté personnalisées disponibles.
4. Prix compétitifs
Prix de gros avantageux avec remises sur volume. Chaîne d'approvisionnement stable pour des partenariats durables.